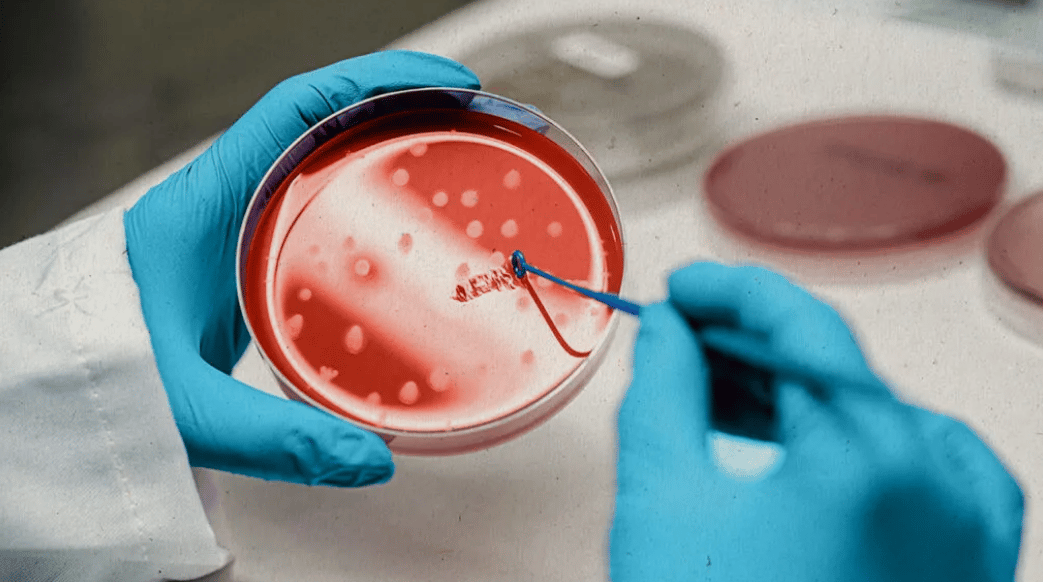

Key Takeaways
- 2022 marked pivotal progress in islet-like cell production and protection.
- Evidence in 2025 remains early-stage but steadily advancing in rigor.
- Safety oversight is strict; avoid unregulated clinics and unproven claims.
- Access mainly runs through monitored clinical trials with narrow criteria.
Stem cell research diabetes gained momentum in 2022 and continues to shape expectations. Researchers now produce insulin-making cells at scale and test devices that shield them from immune attack. Patients and caregivers ask what changed, what is realistic, and how to follow credible progress. This overview summarizes mechanisms, safety, access, and research gaps.
Stem Cell Research Diabetes: What 2022 Taught Us
In 2022, several teams showed more consistent differentiation of pluripotent cells into beta cell–like clusters. Encapsulation systems, including semipermeable devices, aimed to protect these cells from autoimmune and alloimmune responses. These achievements mattered because reliability, durability, and immune evasion are the core hurdles for cell replacement approaches.
Regulators and investigators also tightened trial designs. Studies began to track not only glycemic outcomes but also graft viability, immune markers, and adverse events over longer follow-ups. These shifts established baselines for today’s trials and discouraged the hype that once surrounded miracle-cure narratives. The field moved toward careful, monitored translation rather than shortcuts.
How Stem Cell-Based Therapies Work
Most programs follow a simple idea: replace or restore the pancreas’s insulin-making beta cells. Scientists guide stem cells to become islet-like cells that sense glucose and secrete insulin. Some strategies implant these cells directly, while others house them in devices that allow nutrients and insulin to pass but limit immune cell contact. The long-term goal is durable glucose control with minimal exogenous insulin.
Clinical language calls this diabetes stem cell therapy, while many patients view it as a form of beta-cell replacement. Both refer to attempts to restore endogenous insulin secretion. Success depends on several factors: differentiation quality, oxygen and nutrient delivery, vascularization, immune rejection, and the risk of overgrowth. Each variable must be addressed for sustained function.
Where the Evidence Stands in 2025
Current data remain early but encouraging in specific subgroups. Some participants with long-standing type 1 disease have shown partial C-peptide recovery and reduced insulin needs after cell implantation. What matters most now is durability and safety over multiple years, not short-term responses. Trials are also refining immunosuppression or device barriers to reduce exposure to systemic agents.
A few programs exploring stem cell therapy for type 1 diabetes report improved glycemic markers under tight monitoring, yet generalizability is limited. Evidence for type 2 disease is more preliminary, particularly where insulin resistance remains dominant. Adjunctive therapies may still be necessary. For perspective on emerging drug research that can complement cell strategies, see Orforglipron Clinical Trials for oral incretin context within metabolic disease research.
Safety, Risks, and Oversight
Cell-based products are tightly regulated in North America. The U.S. Food and Drug Administration warns against unapproved regenerative products and emphasizes that legitimate therapies require proper authorization and monitoring. For a balanced overview, see the FDA consumer update that explains how these products are evaluated. Health Canada and other regulators use similar frameworks to control risk and protect patients.
Known risks include surgical complications, infection, immune rejection, device-related issues, and theoretical risks of unwanted cell growth. Transparent consent forms and ongoing surveillance mitigate these concerns. Programs must also plan for graft failure and removal. For background on islet biology and replacement strategies, review NIDDK guidance on beta-cell replacement, which summarizes core scientific principles and ongoing research directions.
Many patients ask about the risks of stem cell therapy for diabetes and how oversight works in practice. Accredited centers employ data safety monitoring boards, independent review, and staged enrollment. Protocols evolve as evidence accumulates, and negative findings are as informative as positive signals. The goal is durable function with acceptable risk.
Access, Costs, and Trial Enrollment
Access generally occurs through monitored studies, not routine clinical care. Enrolling in stem cell clinical trials for diabetes requires meeting narrow criteria related to age, disease duration, hypoglycemia risk, and comorbidities. Most sites limit travel burdens and require frequent follow-ups. Sponsors typically cover research-related procedures, while participants may face ancillary expenses.
Out-of-pocket costs vary by program and location, and investigators cannot promise personal medical benefit. Interested individuals should search vetted registries and ask their clinicians about ongoing studies. For current listings and eligibility filters, consult active U.S. trial listings that aggregate sponsor information. For context on broader diabetes research reporting, our Research archive highlights peer-reviewed updates across therapies.
Who Might Benefit and Who Should Wait
Today’s focus is narrow: individuals with type 1 diabetes who experience impaired awareness of hypoglycemia or severe glycemic variability despite optimized care. This group mirrors past islet transplantation candidates. Even among these candidates, eligibility depends on immune status, organ function, and willingness to undergo intensive follow-up. These programs remain experimental and resource-intensive.
People with insulin-resistant phenotypes may need additional interventions addressing weight and cardiometabolic drivers. Some exploratory studies are testing stem cell therapy for type 2 diabetes in cases with significant beta-cell failure, but evidence is limited. For adjunct strategies that may support glycemic control, see Liraglutide for Type 1 for a review of incretin-based approaches in select populations.
Related Treatments and Combined Approaches
Cell-based strategies often intersect with immunomodulation and device advances. Research explores ways to retrain the immune system, reduce insulitis, and extend graft life. For immune-modulating approaches that could complement cell replacement, see Immunotherapy in Type 1 Diabetes for a grounded overview of mechanisms and early trials.
Some programs evaluate islet cell transplant stem cell diabetes as part of combined regimens, sometimes alongside encapsulation technologies. Delivery tools still matter for day-to-day management. For a look at modern insulin devices, visit Humalog Innovations for delivery advances, and Insulin Cartridges for device basics that support stable dosing while research evolves.
Safety in Everyday Care While Research Advances
Even as cell therapies progress, foundational care remains essential. Continuous glucose monitoring, appropriate insulin titration, and complication screening protect health over time. To support eye health while considering advanced therapies, see Diabetic Retinopathy Strategies for monitoring and prevention guidance. Lifestyle measures still help reduce glycemic variability and cardiometabolic risks.
Nutrition and physical activity can enhance insulin sensitivity and reduce glucose excursions. For practical dietary frameworks that complement medical therapy, review Diet for Insulin Resistance for meal-planning concepts that lower insulin demand. These steps support safety whether or not a person pursues trial participation.
Regulatory Status and What to Watch
No cell-based product for diabetes has broad FDA approval for routine clinical use at this time. Candidates progress through staged trials, and any future application would require robust safety and efficacy data. For broader cardiometabolic implications of newer agents that could pair with cell strategies, see Mounjaro Heart Benefits for insights on cardiovascular outcomes alongside glucose management.
Headlines sometimes promise a type 2 diabetes cure breakthrough or predict timelines. Evidence does not support fixed dates, and regulatory review is methodical. Balanced expectations help patients weigh opportunities without undue risk. Collaboration among endocrinology, immunology, bioengineering, and regulatory science remains the path forward.
Research Gaps and Next Steps
Several gaps remain: durable engraftment without chronic immunosuppression, confirmed long-term safety, and scalable manufacturing. Teams are testing improved differentiation protocols and immune-shielding materials while tracking durability beyond two years. Biomarkers that predict graft success could refine patient selection and reduce exposure for those unlikely to benefit.
Real-world implementation will require training, supply chains, and equitable access. Health systems must plan for post-implant monitoring and define endpoints that matter to patients, such as hypoglycemia reduction and quality of life. Until then, rigorous trials and transparency will continue to guide responsible progress.
Tip: When evaluating programs, ask about regulatory status, funding source, safety monitoring, and publication history before considering enrollment.
This content is for informational purposes only and is not a substitute for professional medical advice.